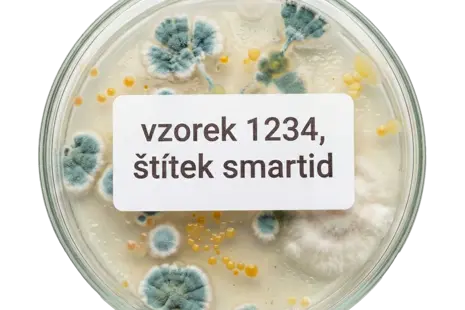
Každý vzorek má svou identitu: Spouštíme specializovaný portál SmartID Lab

Štítky, které drží. Ekosystém, který funguje.
Jsme specializovaný e-shop s kompletním portfoliem produktů Brady. Od odolného průmyslového značení až po komplexní Lockout/Tagout. Naše odborné poradenství vás provede celým sortimentem a pomůže vám sestavit ekosystém na míru vašemu provozu.
Smart iD, s.r.o. je jediným zlatým distributorem značky Brady v České republice.

Produkty
Více než jen tiskárna etiket. Objevte sílu systému Brady.
Produkty Brady jsou navrženy pro ty nejnáročnější aplikace, kde běžná řešení selhávají. Ve Smart iD vám celý systém srozumitelně vysvětlíme, pomůžeme s výběrem a navrhneme kompletní řešení.
Odolné materiály
Hledáte etikety, které skutečně drží i v těch nejtěžších podmínkách?
Materiály a štítky Brady jsou přísně testovány a certifikovány tak, aby bezpečně odolaly vysokým teplotám, agresivním chemikáliím, olejům, silnému oděru i UV záření. Zajišťují spolehlivou výdrž tam, kde běžné samolepky selhávají.
Ekosystém tisku
Chytré propojení materiálu, tiskárny etiket a softwaru pro tisk bez starostí.
Vaše chytrá tiskárna okamžitě rozpozná vloženou pásku (Drop & Lock). Spotřební materiál automaticky komunikuje s tiskárnou i PC. Parametry a kalibrace se nastaví samy. Vy jen zadáte text a tisknete – absolutně bez zdržování.
Chytrý software
Využijte plný potenciál pro tvorbu etiket a chytrou automatizaci značení.
Profesionální software vám umožní snadno automatizovat značení přímo v rámci výroby. Můžete plynule propojovat data z vašich interních systémů a efektivně tisknout tisíce štítků bez rizika lidské chyby.
Co pro vás znamená, že jsme jediný Zlatý distributor v ČR?
Náš status Gold Partnera není jen odznak na webu. Je to garance nejvyšší kvality, čerstvosti materiálů a bezkonkurenční technické podpory s přímým napojením na inženýry z Brady Corporation.
Garance "čerstvého" materiálu
Nekupujte skladové ležáky. Zaručujeme 100% čerstvost a maximální přilnavost všech dodaných materiálů.
Věděli jste, že adhezivum na nenalepených etiketách časem degraduje? Pokud štítek leží na nosném papíru déle než dva roky, vlivem vzduchu začíná lepidlo předčasně tuhnout. K vytvrzení má přitom dojít až po aplikaci na finální povrch. Proto garantujeme, že u nás nekupujete letité „skladové ležáky“. Materiál točíme průběžně přímo od výrobce, a vy tak máte jistotu čerstvého lepidla s maximální výdrží a spolehlivostí i v těch nejnáročnějších podmínkách.
Certifikovaní experti
Náš špičkově proškolený tým vám navrhne to nejlepší řešení přesně pro váš specifický provoz.
Získat status Zlatého distributora znamená mít tým, který musí splňovat přísná kritéria přímo od centrály Brady. Naši specialisté se perfektně orientují v tisících produktech a znají chování každého materiálu v praxi. Ať už řešíte značení na potrubí, do extrémního mrazu, nebo na hrubý povrch, vždy vám přesně poradíme, jaké řešení zvolit, abyste neplýtvali penězi za nefunkční alternativy.
Vše pod jednou střechou
Od standardních produktů až po kompletní zakázkovou výrobu štítků zcela na míru.
Pracujeme v těsném a každodenním kontaktu se samotným výrobcem. Díky tomu vám dodáme kompletní sortiment značky Brady bez jakýchkoliv kompromisů a s prioritní podporou. A pokud váš projekt vyžaduje něco zcela speciálního? Bez problémů pro vás zajistíme zakázkovou výrobu štítků na míru – přesně podle vašich technických parametrů, rozměrů a požadovaných odolností. Jsme tu pro vás od A do Z.
Nevěříte? Vyzkoušejte si odolnost etiket ve vašem provozu
Můžeme vám slíbit, že materiály Brady vydrží hodně. Ale nejlepší je přesvědčit se na vlastní kůži. Napište nám, co přesně potřebujete vyřešit, a my pro vás vybereme ideální materiál a pošleme vzorek k otestování zdarma. Nalepte ho na zamaštěné trubky, kabely nebo do mrazáku a pošlete na něj své vlastní stroje.
Chystáte velký projekt? Navrhneme řešení na míru.
Vybavujete novou výrobní halu, zavádíte komplexní systém LOTO pro bezpečnost práce, nebo potřebujete sjednotit chaotické značení napříč celým závodem? Ozvěte se nám. Jako Zlatý distributor zanalyzujeme vaše potřeby, připravíme individuální B2B cenovou nabídku a zajistíme kompletní dodávku techniky i spotřebního materiálu.
Nejnovější články

Co je Lockout/Tagout (LOTO)?
LOTO (Lockout/Tagout) je plánovaná bezpečnostní procedura, která zajišťuje odpojení přívodu energie do průmyslových strojů a zařízení během servisu, údržby nebo oprav. Tento postup chrání pracovníky před riziky spojenými s nečekaným spuštěním stroje nebo uvolněním zbytkové energie.
Každý vzorek má svou identitu: Spouštíme specializovaný portál SmartID Lab
SmartID Lab – specializovaný portál pro profesionální laboratorní značení. Objevte řešení, která odolají tekutému dusíku, autoklávu i agresivní chemii, a zajistěte svým vzorkům stoprocentní identitu.
Bezpečné pracoviště: Kompletní průvodce bezpečnostním značením strojů s produkty Brady
Zajistěte bezpečnost na pracovišti a splňte legislativní požadavky s komplexním řešením pro bezpečnostní značení strojů od společnosti Brady. Tento článek vás provede důležitostí správného značení, legislativními požadavky a normami. Seznámíte se s širokou škálou produktů Brady, včetně tiskáren, odolných materiálů a intuitivního softwaru. Naučíte se, jak efektivně identifikovat rizika, vybrat správné značky a umístit je na stroje. Zjistěte, jak produkty Brady zvyšují bezpečnost, snižují riziko úrazů a šetří náklady.

Značení potrubí v chemickém průmyslu: Brady B-595
Brady B-595 je vysoce odolná vinylová fólie s permanentním lepidlem, ideální pro trvanlivé značení potrubí v náročném chemickém průmyslu. Zajišťuje vynikající přilnavost i na problematických površích a odolává chemikáliím, UV záření, mastnotám a extrémním teplotám.
















